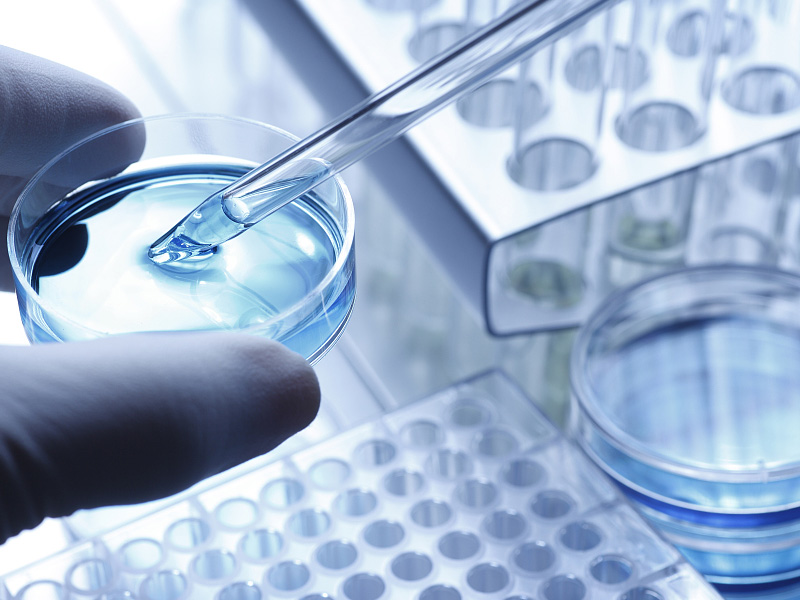
医疗应用

关于我们
安徽禾实新材料科技有限公司成立于2021年2月,注册资金1200万,共16台全自动高效成型机(前期已投入使用 12台,其中EPP1214设备两台,泡沫成型机十台,二期4台,其中3台EPP,泡沫成型机一台),EPS产品年产能达5000吨,EPP产品年产能达720吨,年销售额达1.1亿元,公司地址位于合肥新桥机场5公里寿县新桥国际产业园。 产品有EPS结构件、EPS包装件、EPP、EPO、NEPS等产品,广泛用于家电、电子行业、汽车行业(如保险杠缓冲件)、摩托车头盔、海鲜及疏菜水果保鲜周转箱等。 公司拥有专业产品知识设计能力、具备调试能力的技术力量,通过长期生产实践将先进的EPS、EPP制品生产工艺理念,融入到新厂的生产工艺布局设计、设备选型、生产系统设计、模具工艺设计等,从而将EPS、EPP、EPO产品质量及生产效率领先于同行业,还有高素质敬岗勤业的服务营销队伍。为客户提供全方位的服务,我们将通过与您诚挚合作,共享高质量产品知识成果,为您的企业节省成本,以达到我们共赢的目...
更多